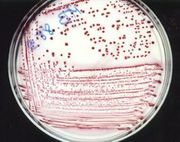

قائمة الملفات
اذهب إلى التنقل
اذهب إلى البحث
هذه الصفحة الخاصة تعرض كل الملفات المرفوعة.
| تاريخ | الاسم | تصغير | الحجم | المستخدم | الوصف | نسخ |
|---|---|---|---|---|---|---|
| 09:26، 22 فبراير 2018 | Mfcd00149972-medium.png (ملف) |  |
27 كيلوبايت | أسيل سيوف (نقاش | مساهمات) | 1 | |
| 07:12، 21 فبراير 2018 | Dihydroxialumini sodium carbonate.png (ملف) |  |
7 كيلوبايت | كنان الطرح (نقاش | مساهمات) | 1 | |
| 23:58، 20 فبراير 2018 | Algeldrate.png (ملف) |  |
2 كيلوبايت | كنان الطرح (نقاش | مساهمات) | 1 | |
| 18:41، 2 فبراير 2018 | Adrenergic Agonists7.png (ملف) |  |
105 كيلوبايت | كنان الطرح (نقاش | مساهمات) | 1 | |
| 18:41، 2 فبراير 2018 | Adrenergic Agonists6.png (ملف) |  |
55 كيلوبايت | كنان الطرح (نقاش | مساهمات) | 1 | |
| 18:40، 2 فبراير 2018 | Adrenergic Agonists5.png (ملف) |  |
64 كيلوبايت | كنان الطرح (نقاش | مساهمات) | 1 | |
| 18:40، 2 فبراير 2018 | Adrenergic Agonists4.png (ملف) |  |
65 كيلوبايت | كنان الطرح (نقاش | مساهمات) | 1 | |
| 18:40، 2 فبراير 2018 | Adrenergic Agonists3.png (ملف) |  |
63 كيلوبايت | كنان الطرح (نقاش | مساهمات) | 1 | |
| 18:40، 2 فبراير 2018 | Adrenergic Agonists2.png (ملف) |  |
84 كيلوبايت | كنان الطرح (نقاش | مساهمات) | 1 | |
| 18:40، 2 فبراير 2018 | Adrenergic Agonists1.png (ملف) |  |
57 كيلوبايت | كنان الطرح (نقاش | مساهمات) | 1 | |
| 17:48، 2 يناير 2018 | ScienceDaily.jpg (ملف) |  |
50 كيلوبايت | أسيل سيوف (نقاش | مساهمات) | 1 | |
| 03:14، 21 ديسمبر 2017 | Bronopol.png (ملف) |  |
2 كيلوبايت | كنان الطرح (نقاش | مساهمات) | 1 | |
| 17:17، 9 ديسمبر 2017 | Melanoma.jpg (ملف) |  |
346 كيلوبايت | كنان الطرح (نقاش | مساهمات) | 1 | |
| 17:16، 9 ديسمبر 2017 | Squamous Cell Carcinoma.jpg (ملف) |  |
32 كيلوبايت | كنان الطرح (نقاش | مساهمات) | 1 | |
| 17:10، 9 ديسمبر 2017 | Basal cell carcinoma.jpg (ملف) |  |
263 كيلوبايت | كنان الطرح (نقاش | مساهمات) | 1 | |
| 14:29، 9 ديسمبر 2017 | Clostridium tetani 2.png (ملف) |  |
404 كيلوبايت | كنان الطرح (نقاش | مساهمات) | 1 | |
| 14:29، 9 ديسمبر 2017 | Clostridium tetani 1.png (ملف) |  |
470 كيلوبايت | كنان الطرح (نقاش | مساهمات) | 1 | |
| 14:23، 9 ديسمبر 2017 | Sporogenes.png (ملف) |  |
407 كيلوبايت | كنان الطرح (نقاش | مساهمات) | 1 | |
| 14:22، 9 ديسمبر 2017 | Perfringens.png (ملف) |  |
257 كيلوبايت | كنان الطرح (نقاش | مساهمات) | 1 | |
| 05:58، 9 ديسمبر 2017 | Acinetobacter.jpg (ملف) |  |
10 كيلوبايت | كنان الطرح (نقاش | مساهمات) | 1 | |
| 04:49، 8 ديسمبر 2017 | Structural Formula.png (ملف) |  |
2 كيلوبايت | كنان الطرح (نقاش | مساهمات) | 1 | |
| 14:02، 2 ديسمبر 2017 | Carbonic anhydrase ea.jpg (ملف) |  |
10 كيلوبايت | كنان الطرح (نقاش | مساهمات) | 1 | |
| 20:24، 13 نوفمبر 2017 | Tetracyclic intraction.png (ملف) |  |
41 كيلوبايت | كنان الطرح (نقاش | مساهمات) | 1 | |
| 20:23، 13 نوفمبر 2017 | TCAs1.png (ملف) |  |
38 كيلوبايت | كنان الطرح (نقاش | مساهمات) | 1 | |
| 20:15، 13 نوفمبر 2017 | TCAs.png (ملف) |  |
33 كيلوبايت | كنان الطرح (نقاش | مساهمات) | 1 | |
| 23:15، 4 نوفمبر 2017 | Stopacid.jpg (ملف) |  |
597 كيلوبايت | إدارة الموسوعة (نقاش | مساهمات) | مادة دعائية لمعمل أدوية | 1 |
| 05:40، 23 أكتوبر 2017 | 37113.jpg (ملف) |  |
19 كيلوبايت | كنان الطرح (نقاش | مساهمات) | 1 | |
| 05:29، 23 أكتوبر 2017 | 37114.jpg (ملف) | |
28 كيلوبايت | كنان الطرح (نقاش | مساهمات) | 1 | |
| 05:28، 23 أكتوبر 2017 | 37112.jpg (ملف) |  |
17 كيلوبايت | كنان الطرح (نقاش | مساهمات) | 1 | |
| 05:26، 23 أكتوبر 2017 | 37111.jpg (ملف) |  |
18 كيلوبايت | كنان الطرح (نقاش | مساهمات) | 2 | |
| 05:39، 9 أكتوبر 2017 | 22330839 1226280274182118 462822328 n.jpg (ملف) |  |
12 كيلوبايت | كنان الطرح (نقاش | مساهمات) | 1 | |
| 05:38، 9 أكتوبر 2017 | 22359133 1226280270848785 1540546593 n.jpg (ملف) |  |
17 كيلوبايت | كنان الطرح (نقاش | مساهمات) | 1 | |
| 02:59، 8 أكتوبر 2017 | 41086tn.jpg (ملف) |  |
10 كيلوبايت | كنان الطرح (نقاش | مساهمات) | 1 | |
| 02:58، 8 أكتوبر 2017 | 41085tn.jpg (ملف) |  |
16 كيلوبايت | كنان الطرح (نقاش | مساهمات) | 1 | |
| 02:56، 8 أكتوبر 2017 | 41088tn.jpg (ملف) |  |
12 كيلوبايت | كنان الطرح (نقاش | مساهمات) | 1 | |
| 02:55، 8 أكتوبر 2017 | 41096tn.jpg (ملف) |  |
15 كيلوبايت | كنان الطرح (نقاش | مساهمات) | 1 | |
| 02:45، 8 أكتوبر 2017 | 41092tn.jpg (ملف) |  |
12 كيلوبايت | كنان الطرح (نقاش | مساهمات) | 1 | |
| 11:20، 6 أكتوبر 2017 | Galactomannan.png (ملف) |  |
14 كيلوبايت | كنان الطرح (نقاش | مساهمات) | 1 | |
| 12:56، 27 سبتمبر 2017 | 1280px-Progesterone during menstrual cycle.png (ملف) |  |
194 كيلوبايت | كنان الطرح (نقاش | مساهمات) | 1 | |
| 21:01، 16 مارس 2017 | Bowl Of Hygieia by David.svg (ملف) |  |
3 كيلوبايت | إدارة الموسوعة (نقاش | مساهمات) | 1 | |
| 09:39، 16 يونيو 2016 | Sarothamnus scoparius.jpg (ملف) |  |
34 كيلوبايت | أسيل سيوف (نقاش | مساهمات) | 1 | |
| 10:23، 11 يونيو 2016 | Mazindol.png (ملف) |  |
7 كيلوبايت | ديما شباط (نقاش | مساهمات) | دواء مضاد للسمنة | 1 |
| 10:22، 11 يونيو 2016 | Mazindol 3D.png (ملف) |  |
45 كيلوبايت | ديما شباط (نقاش | مساهمات) | دواء مضاد للسمنة | 1 |
| 10:13، 11 يونيو 2016 | Furfenorex.png (ملف) |  |
5 كيلوبايت | ديما شباط (نقاش | مساهمات) | دواء مضاد للسمنة | 1 |
| 10:11، 11 يونيو 2016 | Furfenorex 3D.png (ملف) |  |
40 كيلوبايت | ديما شباط (نقاش | مساهمات) | دواء مضاد للسمنة | 1 |
| 10:01، 11 يونيو 2016 | Lisdexamfetamine.png (ملف) |  |
4 كيلوبايت | ديما شباط (نقاش | مساهمات) | دواء مضاد للسمنة | 1 |
| 09:57، 11 يونيو 2016 | Lisdexamfetamine 3D.png (ملف) |  |
49 كيلوبايت | ديما شباط (نقاش | مساهمات) | دواء مضاد للسمنة | 1 |
| 09:44، 11 يونيو 2016 | Fluminorex 3D.png (ملف) |  |
39 كيلوبايت | ديما شباط (نقاش | مساهمات) | دواء مضاد للسمنة | 1 |
| 09:42، 11 يونيو 2016 | Fluminorex.png (ملف) |  |
5 كيلوبايت | ديما شباط (نقاش | مساهمات) | دواء مضاد للسمنة | 1 |
| 01:06، 19 مايو 2016 | Dose response2.gif (ملف) |  |
16 كيلوبايت | حنان الجمال (نقاش | مساهمات) | 1 |